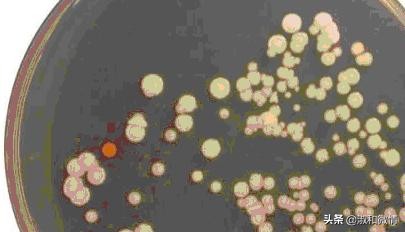
甲硝唑片的说明书用量看不懂,甲硝唑片说明书范文

1
甲硝唑片是一种治疗牙痛的常用药,什么牙龈炎、冠周炎、牙槽脓肿等,其实甲硝唑在临床上的用途很多,请看甲硝唑片的说明书上是如何写的:

甲硝唑片说明书的适应症:
本品用于治疗肠道和肠外阿米巴病(如阿米巴肝脓肿、胸膜阿米巴病等)。还可用于治疗阴道滴虫病、小袋虫病和皮肤利什曼病、麦地那龙线虫感染等。目前还广泛用于厌氧菌感染的治疗。
也许大家有个疑问了,在甲硝唑片的说明书里并没有用于治疗牙龈炎、冠周炎、牙槽脓肿等引起牙痛的适应症,为什么甲硝唑能治疗牙痛呢?
其实甲硝唑之所以能治疗引起牙痛的相关疾病,就在说明书的适应症的最后一句里:
目前还广泛用于厌氧菌感染的治疗。
这个厌氧菌的感染的疾病可就多了,且听我简单的概括一下吧。
2
甲硝唑的抗厌氧菌谱包括脆弱拟杆菌、梭形杆菌、产气芽胞杆菌、消化球菌属和消化链球菌属等。
★ 脆弱拟杆菌正常寄生于人的口腔、肠道和女性生殖道,是一种条件致病菌,主要为内源性感染,可引起女性生殖系统、胸腔和颅内感染、软组织感染、腹部脓肿、菌血症。

★ 梭形杆菌正常寄生于人或动物的口腔、上消化道、肠道及泌尿生殖道和土壤中,以口腔中最为多见。

★ 产气芽胞杆菌广泛存在于土壤,动物和人的肠道,健康人肠道带菌率为2%-5%,带菌人和动物均可污染食物,而成为污染源。通过污染的食物和饮水而引起感染发病。可引起厌氧性蜂窝织炎、泌尿系感染和食物中毒。

★ 消化球菌属是口腔、肠道、女性生殖道、皮肤等处的正常菌群。是一种条件致病菌,常和其他菌混合感染,也可单独感染。在菌血症、手指感染、前列腺炎、乳腺脓肿、肺部感染和各种化脓性感染时均可分离到消化球菌。在一些口腔感染性疾病时,如牙髓感染时也可分离出消化球菌。
★ 消化链球菌是人体口腔、上呼吸道、肠道和女性生殖道的正常菌群,可引起人体各部组织和器官感染,混合感染为多见,如腹腔、盆腔、阴道感染、肝脓肿、肺部、胸膜感染、颅内感染及皮肤和软组织感染等。厌氧消化链球菌常可引起细菌性心内膜炎,与金黄色葡萄球菌、溶血性链球菌可引起严重的创伤感染即厌氧链球菌肌炎。口腔、上呼吸道、肺胸膜感染中可出现,微小消化链球菌寄生于口腔牙缝,直径0.3~0.5um,对糖和蛋白均无反应,常由于拔牙进入血循环引起亚急性细菌性心内膜炎,也常在头颈部、口咽、上呼吸道感染中出现。

以上厌氧菌所引起的疾病均可用甲硝唑进行治疗。
所以说,在口腔中存在的正常的上述厌氧菌,如果其菌群发生改变而引起感染时,使用甲硝唑均可以达到治疗的效果。
3
甲硝唑片说明书中其它的适应症均是治疗原虫类微生物引起的相关疾病,也作一下简要介绍吧。
★ 阿米巴原虫生活于水、泥土或腐败有机物中。肠道阿米巴病是溶组织内阿米巴所致的肠道感染,主要病变部位在近端结肠和盲肠。临床表现轻重悬殊,典型表现有粘液血便等痢疾样症状,称为阿米巴痢疾,非典型表现有阿米巴肠炎,阿米巴瘤,阿米巴性阑尾炎以及爆发性结肠炎等。

★ 肠外阿米巴病包括阿米巴肝脓肿、肺脓肿、脑脓肿,皮肤阿米巴病以及阿米巴性心包炎、阴道炎、尿道炎、前列腺炎等,其中以阿米巴肝脓肿最为常见。
★ 滴虫病是由毛滴虫引起,寄生人体的毛滴虫有三种:阴道毛滴虫,人毛滴虫和口腔毛滴虫;分别寄生于泌尿生殖系统、肠道和口腔,阴道毛滴虫,引起滴虫性阴道炎。在男性引起尿道炎和前列腺炎。

★ 小袋虫是寄生在人体结肠引起的一种常见寄生原虫性疾病,临床表现为腹痛,腹泻,黏液脓血便、里急后重、发热等,慢性迁延性病人则表现为便秘与腹泻交替或周期性腹泻。

★ 皮肤利什曼病是由多种不同的利什曼原虫感染引起的皮肤损害。多见于男性青壮年,农民居多。多数患者有明确黑热病史。好侵犯皮肤和黏膜,无全身症状。皮损以红斑、斑块和结节为主,也可表现为色素减退斑、浅色斑或溃疡。病程极慢。

★ 麦地那龙线虫雌虫一般长约70~80cm,极少超过100cm,人类饮用被污染的水源后,龙线虫幼虫进入人体,从而完成它的生命周期。本虫的致病主要是雌虫移行至皮肤,使皮肤出现条索状硬结和肿块;雌虫释放的幼虫可引起丘疹、水泡、脓泡、蜂窝组织炎、脓肿、溃疡等症状;雌虫释放的产物可引起*麻疹荨**,血管性水肿和全身症状,发热、头晕、恶心、腹泻、血中嗜酸性粒细胞增高。后遗症有关节炎、滑膜炎、关节强直和患肢萎缩,影响劳力。

甲硝唑虽然有如此广泛的药理作用,但它是处方药,其副作用亦不可小嘘,因此在使用甲硝唑之前一定要咨询医师或药师,切记切记!